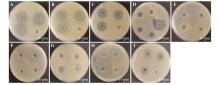

Bulletin of Botanical Research ›› 2025, Vol. 45 ›› Issue (3): 433-446.doi: 10.7525/j.issn.1673-5102.2025.03.013
• Original Paper • Previous Articles Next Articles
Kunlin ZOU1,2, Siyuan JIANG1,2, Yajing WEI1,2, Shun ZHANG1,2, Peng LI3, Jing YIN1,2( )
)
Received:2024-11-06
Online:2025-05-20
Published:2025-05-23
Contact:
Jing YIN
E-mail:yinjing20135@163.com
CLC Number:
Kunlin ZOU, Siyuan JIANG, Yajing WEI, Shun ZHANG, Peng LI, Jing YIN. Evaluation of Antioxidant, Anti-ultraviolet Radiation, and Antibacterial Functions of Endophytic Extracts from Different Plant Sources[J]. Bulletin of Botanical Research, 2025, 45(3): 433-446.
Add to citation manager EndNote|Ris|BibTeX
URL: https://bbr.nefu.edu.cn/EN/10.7525/j.issn.1673-5102.2025.03.013
Fig.4
Antibacterial activity of ethyl acetate extracts from fermentation broths(A-E) and anhydrous ethanol extracts from mycelia(F-I) of different endophytic fungiA. ZJ29 inhibited E.coli; B. ZJ29 inhibited S. aureus; C. ZJ29 inhibited B. subtilis; D. XZ13-2 inhibited E. coli; E. XZ13-2 inhibited S. aureus; F. XZ13-2 inhibited E. coli; G. ZJ29 inhibited E. coli; H. YZ8-3 inhibited E. coli; I. ZJ29 inhibited S. aureus. In the antibacterial assay(result D),the inhibition zone observed in the rightmost well was generated by the positive control ampicillin(50 mg?L?1), while all other wells(A-C and E-I) were treated with the negative control(absolute ethanol) only.

| 1 | 吴琼,王雷,曹涤非,等.汉麻内生菌的研究进展[J].农业与技术,2022,42(5):25-27. |
| WU Q, WANG L, CAO D F,et al.Research progress of endophytic bacteria of Chinese hemp[J].Agriculture and Technology,2022,42(5):25-27. | |
| 2 | 胡倩楠.荒漠植物深色有隔内生真菌物种多样性及耐旱性研究[D].保定:河北大学,2023. |
| HU Q N.Species diversity and drought tolerance of dark septate endophytes fungi in desert plants[D].Baoding:Hebei University,2023. | |
| 3 | 甘俊丽.黄草乌内生真菌黑曲霉(Aspergillus niger B-30)次生代谢产物及活性研究[D].昆明:云南大学,2022. |
| GAN J L.Secondary metabolites analysis and their bioactivities of the endophytes fungus(Aspergillus niger B-30) associated with Aconitum vilmorinianum Kom[D].Kunming:Yunnan University,2022. | |
| 4 | 杨星.山豆根内生真菌TRXY-46抑菌次生代谢产物研究[D].南宁:广西大学,2020. |
| YANG X.Research on the antagonistic phytopathogen secondary metabolites of endophytic fungi TRXY-46 from Sophora tonkinensis [D].Nanning:Guangxi University,2020. | |
| 5 | 郑有坤,刘凯,熊子君,等.药用植物内生放线菌多样性及天然活性物质研究进展[J].中草药,2014,45(14):2089-2099. |
| ZHENG Y K, LIU K, XIONG Z J,et al.Research progress on biodiversity of endophytic actinobacteria in medicinal plants and their bioactive substances[J].Chinese Traditional and Herbal Drugs,2014,45(14):2089-2099. | |
| 6 | ZHANG H W, SONG Y C, TAN R X.Biology and chemistry of endophytes[J].Natural Product Reports,2006, 23(5):753-771. |
| 7 | 卜宣尹,杨卫丽.植物内生菌抑菌机制和抑菌次生代谢产物的研究进展[J].现代药物与临床,2021,36(10):2200-2206. |
| BU X Y, YANG W L.Research progress on antibacterial mechanism of plant endophytes and antibacterial secondary metabolites[J].Drugs & Clinic,2021,36(10):2200-2206. | |
| 8 | FISHER P J, ANSON A E, PETRINI O.Fungal endophytes in Ulex europaeus and Ulex gallii [J].Transactions of the British Mycological Society,1986,86(1):153-156. |
| 9 | 陈洁梅,缪冰旋,张灿辉,等.野生葡萄及葡萄酒抗氧化活性和抗菌性研究[J].广西植物,2014,34(4):510-514. |
| CHEN J M, MIAO B X, ZHANG C H,et al.Antioxidant activity and antibacterial property of wild grape and grape wine[J].Guihaia,2014,34(4):510-514. | |
| 10 | LU H, ZOU W X, MENG J C,et al.New bioactive metabolites produced by Colletotrichum sp.,an endophytic fungus in Artemisia annua [J].Plant Science,2000,151(1):67-73. |
| 11 | 杨雨微,周向平,袁志辉,等.银杏内生菌及其次生代谢产物多样性和生防活性的研究进展[J].安徽农业科学,2024,52(22):20-28. |
| YANG Y W, ZHOU X P, YUAN Z H,et al.Endophytes of Ginkgo biloba and its secondary metabolites diversity and biocontrol activity[J].Journal of Anhui Agricultural Sciences,2024,52(22):20-28. | |
| 12 | 苏天骄.川贝母基源植物内生真菌及其次生代谢物生物活性研究[D].雅安:四川农业大学,2018. |
| SU T J.Biological activities of endophytic fungi and their metabolites from the original plants of Fritillariae Cirrhosae Bulbus[D].Ya’an:Sichuan Agricultural University,2018. | |
| 13 | MECHOULAM R, GAONI Y.Recent advances in the chemistry of hashish[J].Fortschritte der Chemie Organischer Naturstoffe,1967,25:175-213. |
| 14 | 张政帅,周学明,田欣,等.角果木来源内生真菌 Penicillium herquei JX4中聚酮类次级代谢产物的 抗菌性[J].海南师范大学学报(自然科学版),2025,38(1):10-13. |
| ZHANG Z S, ZHOU X M, TIAN X,et al.Antibacterial activity of secondary metabolites of polyketones from Ceriops tagal-derived endophytic fungus Penicillium herquei JX4[J].Journal of Hainan Normal University (Natural Science),2025,38(1):10-13. | |
| 15 | 王静,赵浩军,刘梦龙,等.地茶属地衣内生真菌次级代谢产物抑菌、抗氧化活性研究[J].中成药,2024, 46(7):2429-2433. |
| WANG J, ZHAO H J, LIU M L,et al.Study on the inhibitory and antioxidant activities of secondary metabolites of endophytic fungi in lichen of Diecantha genus [J].Chinese Traditional Patent Medicine,2024,46(7):2429-2433. | |
| 16 | 尹诗雨,郭砚.天然植物提取物对皮肤光老化的保护作用[J].临床医学进展,2022,12(1):726-731. |
| YIN S Y, GUO Y.Protective effect of natural plant extracts on skin photoaging[J].Advances in Clinical Medicine,2022,12(1):726-731. | |
| 17 | 曹森,王婷,高天,等.叶底珠内生真菌提取物的抗炎镇痛和抗氧化活性研究[J].药物评价研究,2021, 44(6):1232-1239. |
| CAO S, WANG T, GAO T,et al.Study on anti-inflammatory,analgesic and antioxidative activities of extracts from Securinega suffruticosa [J].Drug Evaluation Research,2021,44(6):1232-1239. | |
| 18 | 吴凯宾.抗氧化在化妆品行业的应用进展[J].化工设计通讯,2019,45(6):143-146. |
| WU K B.Research on the application progress of antioxidant in cosmetics industry[J].Chemical Engineering Design Communications,2019,45(6):143-146. | |
| 19 | 许先猛,董文宾,卢军,等.蒲公英的化学成分和功能特性的研究进展[J].食品安全质量检测学报,2018(7):1623-1627. |
| XU X M, DONG W B, LU J,et al.Research progress on the chemical compositions and functional properties of dandelion[J].Journal of Food Safety and Quality,2018(7):1623-1627. | |
| 20 | 张歌珂.植物源舒缓活性物质的筛选及其活性研 究[D].无锡:江南大学,2023. |
| ZHANG G K.Screening and activity study of soothing substances from plants[D].Wuxi:Jiangnan University,2023. | |
| 21 | 吴以禄,钟怡莹,陈忻,等.山竹果皮在化妆品领域应用前景研究[J].广东化工,2022,49(19):129-131. |
| WU Y L, ZHONG Y Y, CHEN X,et al.The application of mangosteen peel in cosmetics field[J].Guangdong Chemical Industry,2022,49(19):129-131. | |
| 22 | 黄振帝,苗华彪,裴丁玉,等.松口蘑的活性成分及其研究进展[J].菌物学报,2023,42(10):2025-2040. |
| HUANG Z D, MIAO H B, PEI D Y,et al.Active components and their research progress of Tricholoma matsutake [J].Mycosystema,2023,42(10):2025-2040. | |
| 23 | MWANGI J K.The impact of rice blast disease,its mapping and suitability analysis for rice growing sites in the greater Mwea Region[D].Nairobi:Jomo Kenyatta University of Agriculture and Technology,2014. |
| 24 | THAIPONG K, BOONPRAKOB U, CROSBY K,et al.Comparison of ABTS,DPPH,FRAP,and ORAC assays for estimating antioxidant activity from guava fruit extracts[J].Journal of Food Composition and Analysis,2006,19(6/7):669-675. |
| 25 | 杜小豪,徐卫.防晒化妆品防晒效果评价方法——紫外吸光度法的研究[J].日用化学工业,1998(3):43-46. |
| DU X H, XU W.The method of sunscreen effect evaluation of cosmetics:ultra-violet spectroscopy[J].China Surfactant Detergent & Cosmetics,1998(3):43-46. | |
| 26 | 李祥荣.海洋真菌抗副溶血弧菌活性菌株的筛选及其活性物质的初步研究[D].连云港:江苏海洋大学,2022. |
| LI X R.Screening of marine fungi active strains against Vibrio parahaemolyticus and preliminary study on their active substances[D].Lianyungang:Jiangsu Ocean University,2022. | |
| 27 | 柳成东,赵平,王乙茹,等.凝结芽孢杆菌抑菌性能的研究进展[J].饲料工业,2021,42(10):58-64. |
| LIU C D, ZHAO P, WANG Y R,et al.Research progress on antibacterial properties of a probiotic Bacillus coagulans [J].Feed Industry,2021,42(10):58-64. | |
| 28 | 周曼,曹唯仪,王玉蓉.葡萄籽中多酚类物质提取工艺的研究[J].中医药信息,2012,29(1):53-55. |
| ZHOU M, CAO W Y, WANG Y R.The extraction process of polyphenols from grape seed[J].Information on Traditional Chinese Medicine,2012,29(1):53-55. | |
| 29 | 陶海腾,陈晓明,吕飞杰,等.木薯叶黄酮类化合物提取研究[J].食品研究与开发,2009,30(12):12-15. |
| TAO H T, CHEN X M, LÜ F J,et al.Study on the extraction of flavonoids from cassava leaves[J].Food Research and Development,2009,30(12):12-15. | |
| 30 | 李春晓,尹静,詹亚光,等.水分、氮肥及MeJA处理对白桦三萜积累特性的影响[J].西北植物学报,2012,32(1):155-161. |
| LI C X, YIN J, ZHAN Y G,et al.Effects of water,nitrogen and methyl jasmonate treatment on triterpenes accumulation in birch (Betula platyphylla Suk.)[J].Acta Botanica Boreali-Occidentalia Sinica,2012,32(1):155-161. | |
| 31 | 黄颖,孟慧,何欣,等.沉香属植物内生真菌多样性及功能研究进展[J].中草药,2024,55(4):1397-1406. |
| HUANG Y, MENG H, HE X,et al.Research progress on diversity and functions of endophytic fungi in Aquilaria genus[J].Chinese Traditional and Herbal Drugs,2024,55(4):1397-1406. | |
| 32 | 祁鹤兴,李红芳,邹海涛,等.青贮玉米来源镰刀菌的分离鉴定及其致病性分析[J/OL].分子植物育种,(2023-10-17)[2024-12-30].. |
| QI H X, LI H F, ZOU H T,et al.Identification and pathogenicity analysis of Fusarium pathogens from silage maize[J/OL].Molecular Plant Breeding,(2023-10-17) [2024-12-30].. | |
| 33 | 金哲雄,廖薇,张闯,等.引起山核桃干腐病的镰刀菌鉴定[J].植物病理学报,2024,54(2):443-446. |
| JIN Z X, LIAO W, ZHANG C,et al.Identification of Fusarium oblongum causing trunk canker disease on Carya cathayensis [J].Acta Phytopathologica Sinica,2024, 54(2):443-446. | |
| 34 | 韦凯,梁莉,王萌,等.芒果叶中芒果苷抗氧化及抗紫外能力的研究[J].食品安全导刊,2024(32):80-82. |
| WEI K, LIANG L, WANG M,et al.Study on the antioxidant and UV resistance of mangiferin in mango leaves[J].China Food Safety Magazine,2024(32):80-82. | |
| 35 | 贾景辉.基于酪氨酸酶抑制活性的槐耳次级代谢产物研究[D].沈阳:辽宁大学,2023. |
| JIA J H.Studied on the bioactive secondary metabolites from Huai’er with tyrosinase inhibitory activity [D].Shenyang:Liaoning University,2023. | |
| 36 | 张雪,李雪峰,胡瑞峰,等.具有抑制酪氨酸酶活性 乳酸菌的筛选及其成分分析[J].食品科学,2023, 44(18):193-199. |
| ZHANG X, LI X F, HU R F,et al.Screening and compositional analysis of lactic acid bacteria with tyrosinase inhibitory activity[J].Food Science,2023,44(18):193-199. | |
| 37 | 徐彤,姚雪丹,王玉苗,等.盐水球菌Salinicoccus ventosaetal B2-3-5的代谢产物分析及其抑制酪氨酸酶活性的机制[J].微生物学通报,2021,48(10):3753-3764. |
| XU T, YAO X D, WANG Y M,et al.Analysis of metabolites from Salinicoccus ventosaetal B2-3-5 and their inhibitory mechanism of tyrosinase activity[J].Microbiology China,2021,48(10):3753-3764. | |
| 38 | 龙赟而,潘瑞雪,赵一宁,等.一株海洋源皮特不动杆菌的分离鉴定及其全基因测序分析[J/OL].微生物学通报,(2024-12-5)[2024-12-30].. |
| LONG Y E, PAN R X, ZHAO Y N,et al.Isolation,identification,and whole genome sequencing of a marine-derived strain of Acinetobacter pittii [J/OL].Microbiology China,(2024-12-5) [2024-12-30].. | |
| 39 | 戴万生,杨丽,邱斌,等.DPPH法评价黄精及炮制品抗氧化活性方法的研究[J].辽宁中医杂志,2024,51(5):152-154. |
| DAI W S, YANG L, QIU B,et al.Study on DPPH method for evaluating antioxidant activity of Huangjing(Rhizoma Polygonati) and its processed products[J].Liaoning Journal of Traditional Chinese Medicine,2024,51(5):152-154. | |
| 40 | 胡宇航,陈梁,罗翌元,等.三叶青茎部不同溶剂提取物的功能成分、抗氧化及酪氨酸酶抑制活性研究[J].食品安全质量检测学报,2023,14(10):173-181. |
| HU Y H, CHEN L, LUO Y Y,et al.Functional components,antioxidant activity and tyrosinase inhibitory activity of extracts from different solvent extracts from stems of Tetrastigma hemsleyanum Diels et Gilg[J].Journal of Food Safety and Quality,2023,14(10):173-181. | |
| 41 | 王琪.罗汉果内生菌产胞外多糖菌株的筛选及其抗氧化与降糖活性研究[D].桂林:广西师范大学,2021. |
| WANG Q.Selection of exopolysaccharide-producing strains from endophytic bacteria in Siraitia grosvenorii and antioxidant and hypoglycemic activity of exopolysaccharide[D].Guilin:Guangxi Normal University,2021. | |
| 42 | 姜中宝,黄宣雅,唐振兴,等.具有抑菌和抗氧化活性紫金牛内生菌的筛选鉴定[J].杭州师范大学学报(自然科学版),2023,22(5):497-504. |
| JIANG Z B, HUANG X Y, TANG Z X,et al.Screening and identification of endophytes with antibacterial and antioxidant activities from Ardisia japonica [J].Journal of Hangzhou Normal University (Natural Science Edition),2023,22(5):497-504. | |
| 43 | 宋勇,顾玉琴,李小玉,等.一株鱼腥草内生真菌的菌种鉴定及抑菌活性初探[J].现代预防医学,2018, 45(11):2052-2055. |
| SONG Y, GU Y Q, LI X Y,et al.Identification and the antimicrobial activity of an endophytic fungus isolated from Houttuynia cordata Thunb[J].Modern Preventive Medicine,2018,45(11):2052-2055. | |
| 44 | 裴晓燕.红树莓内生真菌次级代谢产物的抑菌活性研究[D].兰州:西北师范大学,2024. |
| PEI X Y.Study on antibacterial activity of secondary metabolites from endophytic fungi of red raspberry[D].Lanzhou:Northwest Normal University,2024. |
| [1] | Xiangchen MA, Ping ZHANG, Yuxin CHEN, Lei JIN. Antioxidant Activity of Polyphenol Extracts from Ten Lily Bulbs and Its Correlation with Environmental Factors [J]. Bulletin of Botanical Research, 2025, 45(2): 315-328. |
| [2] | Yuxin YAN, Meijun HE, Yu LI, Xiaoman YUAN, Xuhui TAN, Ming CHENG, Kai LUO, Lujing LIAO. Whitening and Antioxidant Activities of Leaf Polysaccharide from Dendrobium officinale [J]. Bulletin of Botanical Research, 2025, 45(1): 111-118. |
| [3] | Chenjing SHEN, Wenbo WU, Luran GENG, Fulong WANG, Pengzhou ZHAO, Jinhui SONG, Yaguang ZHAN, Jing YIN. Regulatory Effects of Salicylic Acid,Nano-zinc Oxide and Growth-promoting Fungi YZ13-1 on the Resistance to Drought Stress of Fraxinus mandshurica [J]. Bulletin of Botanical Research, 2023, 43(3): 388-395. |
| [4] | Zhihui HUANG, Yining ZHANG, Nana LI, Baojiang ZHENG, Yuhong ZHANG. Responses of Supplemental UV-B Radiation to Physiological Properties and Secondary Metabolites of Thlaspi arvense [J]. Bulletin of Botanical Research, 2022, 42(6): 1079-1087. |
| [5] | ZHANG Li-Fan, XUE Yu, WANG Yan, YANG Guang-Xin, YANG Guang, DI Xue-Ying. External Antioxidant Activity of Ethanol Extract from Pinus sylvestris var. mongolica [J]. Bulletin of Botanical Research, 2019, 39(3): 458-465. |
| [6] | FAN Yan-Min, DANG Shi-Kun, WANG Wen-Jie, WANG Hui-Mei. Effect of Carbon Source, Auxin and Elicitor on the Growth and Synthesis of Secondary Metabolites of Adventitious Roots of Cajanus cajan(Linn.) Millsp. [J]. Bulletin of Botanical Research, 2018, 38(3): 391-398. |
| [7] | DI Xue-Ying, JIA Shu-Han, XUE Yu, YANG Guang, ZHAO Bo, WENG Yue-Tai. Antioxidant Activities of Polysaccharides from Cronartium orientale Aeciospores in vitro [J]. Bulletin of Botanical Research, 2017, 37(4): 628-634. |
| [8] | WANG Meng-Liang, JIAO Jin, XING Jie, TIAN Jun-Sheng, CUI Jin-Long, WANG Jun-Hong. Effects of Endophytic Fungi ZPRa-R-1 on the Key Singnal Molecules and the Main Secondary Metabolites in Rhodiola crenulata [J]. Bulletin of Botanical Research, 2016, 36(3): 416-420. |
| [9] | ZAN Zhi-Hui;GAO Yan-Mei;SUN Mo-Long. Extraction and Antioxidant Activity of Tannic in Juglans mandshurica Maxim. [J]. Bulletin of Botanical Research, 2015, 35(3): 431-435. |
| [10] | LI Min;QU Dan;YU Hai-Di;WANG Hui-Mei*. Characteristics and Biochemical Indexes of Cajanus cajan Hairy Root [J]. Bulletin of Botanical Research, 2014, 34(3): 339-342. |
| [11] | SUN Shou-Hui;LI Wei;LÜChang-Li;GAO Guo-Ping;Qi Jin-Yu;XU Zhe. Extraction and Analysis of Secondary Metabolites in Poplar Phloem [J]. Bulletin of Botanical Research, 2009, 29(1): 120-123. |
| [12] | YANG Bei-Fen;JIN Ze-Xin*;SHAO Hong;LI Jun-Min. Analysis of Secondary Metabolites Contents in the Different Organs of Heptacodium miconioides [J]. Bulletin of Botanical Research, 2007, 27(2): 229-232. |
| [13] | ZHOU Quan-Cheng, CHEN Guo-Xiang, CHEN Li, WANG Jian-An, ZHANG Cheng-Jun, LÜ Chuan-Gen. Study on antioxidation system in high yield hybrid rice Langyoupeijiu seedlings under dry raising conditions [J]. Bulletin of Botanical Research, 2005, 25(1): 80-85. |
| Viewed | ||||||
|
Full text |
|
|||||
|
Abstract |
|
|||||